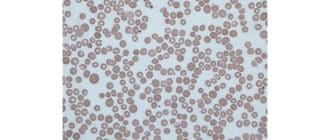

頭部外傷は直ちに医師の診察を必要とする。場合によっては、硬膜外血腫と呼ばれる脳内の出血を発症することがあります。 未治療のまま放置すると、硬膜外血腫が生命を脅かす可能性があります。頭部外傷を患っている人が、この可能性のあ […]
髄膜炎は、脳および脊髄を取り囲む保護膜または髄膜の腫脹を引き起こす状態である。無菌性髄膜炎は、細菌感染以外の何かが髄膜炎を引き起こすときです。ほとんどの場合、ウイルスの結果です。 誰かが無菌性髄膜炎を起こすと、髄膜炎は細 […]
アッパー症候群は、胎児の顔面および頭蓋骨をその発生の早い時期に融合させる稀な遺伝的障害である。 アパート症候群は顔面や頭蓋の異常を引き起こし、視覚障害や歯の問題を引き起こす可能性があります。アパート症候群はまた、指および […]
C型肝炎は人の肝臓を損傷する感染症です。これはHCVとして知られるC型肝炎ウイルスが血流に入るときに発生します。急性C型肝炎は、HCVと接触する人の2週間から6ヶ月以内に発症する場合です。 急性C型肝炎はしばしば慢性C型 […]
赤血球のサイズが不均一である場合、偽喘息は病状です。 「アニソ」は不等であることを意味し、「細胞症」は細胞の動き、特徴または数を指す。 細胞が不平等になる可能性のあるいくつかの異なる方法があるので、偽細胞傷害自体は非特異 […]
肛門裂肛は、肛門管の内面にある肛門裂または亀裂であり、肛門管にまで延びる肛門の切開または裂傷である。 それは、排便中および後に痛みを引き起こすことがあり、便に血液が存在する可能性があります。 ほとんどの肛門裂は1センチメ […]
ヨウ素は、いくつかの消毒剤およびX線処置に使用されるいくつかの化学物質で使用される化合物である。一部の人々はヨウ素に対する重大な不耐性を有することがあるが、アレルギー反応として分類されていない。 ヨードは甲状腺機能に必須 […]
黄体は、卵巣で形成され、妊娠初期のホルモンであるプロゲステロンの産生を担う細胞の塊である。 黄体の役割は、受精の有無に依存する。 時には、嚢胞が黄体に形成され、痛みを伴う症状を引き起こすことがあります。これらの嚢胞は自分 […]
双子座の子宮は、女性が心臓型の子宮を持つ場合に発生します。したがって、この状態は「ハート型子宮」と呼ばれることがあります。 女性の体の子宮は、受精卵が成長して乳児になる臓器です。 女性の子宮の形は、彼女が妊娠中だけでなく […]
皮膚の角などの皮膚上での成長を開発することが懸念の原因となり得る。 皮膚角の約60%は良性であるが、残りのパーセンテージは癌性または前癌性である。このため、皮膚角を持つ人は医師の診察を受けるべきです。 それはどのように見 […]
胸部生検は、乳癌について検査される乳房組織または細胞のサンプルの除去である。医師は、異常なマンモグラムや乳房の塊があれば、生検を勧めます。 医師は、皮膚の陥凹、肥厚、肥厚、痂皮のような乳頭の変化がある場合、乳房生検を助言 […]
bifid uvulaは、口蓋屋の柔らかい口蓋の端にぶら下がっている口蓋垂または組織の異常な分裂または分裂である。医師が口蓋垂を確認するために赤ちゃんの口の中を見るとき、二頭の口蓋垂は通常出生時に識別されます。 場合によ […]
運動失調は、発語、眼球運動、嚥下能力、歩行能力、対象物の拾い上げ能力、および他の随意運動に影響する筋肉調整の欠如である。 多発性硬化症、頭部外傷、アルコール乱用、脳卒中、脳性麻痺、遺伝学、または腫瘍を含む多くの異なる事象 […]
研究は、妊娠を制御する上で免疫システムの前面と中心を置きます。しかし、ウイルスやバクテリアがそれを凌駕することがあり、時には悲惨な結果につながることもあります。 妊娠中、母親の免疫系は常に流動的です。 健康な妊娠をサポー […]
耳鼻咽喉科医は、耳、鼻、喉、および関連する身体構造の疾患および障害の治療および管理に特化した医師である。 耳鼻咽喉科医は、一般的にENT(耳、鼻、および喉)の医師と呼ばれ、医学的および外科的ケアの両方を提供する。 アメリ […]
ホルモンは体内で重要な役割を果たします。彼らは成長を含むほとんどすべての主要な身体機能を制御する役割を果たす。彼らの体が十分に生産しない場合、人は成長ホルモン注射を必要とするかもしれません。 異なるホルモンは、様々な身体 […]
脳の老化はある程度避けられませんが、一様ではありません。それはみんな、あるいはすべての脳に違った影響を与えます。脳の老化を遅くするか、それを完全に止めれば、永遠の若さを達成する究極のエリキシルになります。脳の老化は、私た […]
インフルエンザは単なる「インフルエンザのバグ」以上のものです。それは、鼻、喉、および肺を攻撃し、人を病院に送ることさえできる、非常に伝染性の呼吸器疾患である。高齢者や非常に若い人にとって、インフルエンザは生命を脅かす可能 […]
グルテン運動失調症は、グルテンを消化すると放出される抗体が間違って脳の一部を攻撃する自己免疫障害である。 グルテンは小麦、ライ麦、大麦に含まれるタンパク質です。大部分の人々はこのタンパク質を消化するのに問題はありませんが […]
エクササイズは、健康で快適に過ごしたいすべての人々にとって日常生活の重要な部分です。しかし、パーキンソン病の人にとっては、健康を維持すること以上のものです。彼らのために、右の練習は、移動性やバランスを維持するなど日々の生 […]
我々が怒ると、心拍数、動脈緊張およびテストステロン産生が増加し、コルチゾール(ストレスホルモン)が減少し、脳の左半球がより刺激されるようになります。これは、バレンシア大学(UV)の科学者による新しい調査指導で示されており […]